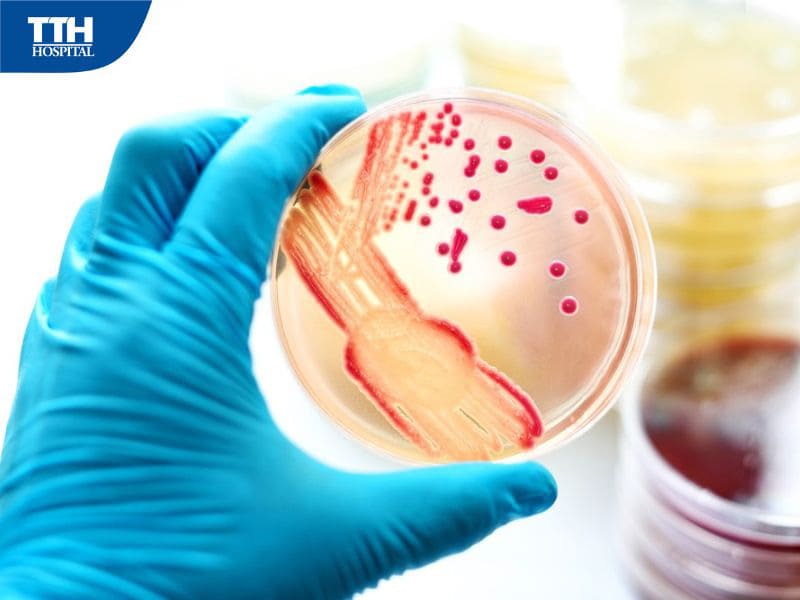
Cách chẩn đoán nhiễm trùng huyết

Nhiễm trùng huyết: Nguyên nhân, triệu chứng và phương pháp điều trị hiệu quả
Nhiễm trùng huyết: Nguyên nhân, triệu chứng và phương pháp điều trị hiệu quả
Nhiễm trùng huyết còn có tên gọi khác là nhiễm trùng máu, là tình trạng cấp cứu y tế, cần can thiệp điều trị kịp thời để ngăn biến chứng nguy hiểm.
1. Nhiễm trùng huyết là gì?
Nhiễm trùng huyết là tình trạng xảy ra khi cơ thể phản ứng cực đoan đối với nhiễm trùng. Theo cơ chế thông thường, khi bị nhiễm trùng thì hệ thống miễn dịch sẽ tăng cường hoạt động để chống lại các tác nhân xâm nhập. Tuy nhiên, khi cơ thể bị nhiễm trùng huyết, hệ miễn dịch không chỉ chống lại các tác nhân gây hại mà còn tấn công gây hại luôn các mô, cơ quan, thúc đẩy tình trạng viêm lan rộng khắp cơ thể.
Ngoài ra, phản ứng dây chuyền bất thường trong hệ thống đông máu cũng dễ kích hoạt hình thành các cục máu đông trong mạch máu, làm tắc nghẽn, giảm lưu lượng máu đến các cơ quan khác và gây tổn thương nghiêm trọng, thậm chí là suy tim, đột quỵ.
2. Nguyên nhân dẫn đến nhiễm trùng huyết
Một trong những nguyên nhân chủ yếu dẫn đến nhiễm trùng huyết là do vi khuẩn. Bên cạnh đó, nhiễm nấm, ký sinh trùng, virus cũng có thể là nguyên nhân gây bệnh. Nhiễm trùng đường huyết có thể bắt đầu ở nhiều bộ phận khác nhau, có thể như:
-
Hệ hô hấp
Khi bị nhiễm trùng liên quan đến phổi dễ dẫn đến viêm phổi, nếu không được điều trị kịp thời sẽ có khả năng dẫn đến nhiễm trùng huyết.
-
Hệ tiết niệu
Trường hợp nhiễm trùng đường tiết niệu nặng cũng tiềm ẩn nguy cơ dẫn đến nhiễm trùng huyết, nhất là trong trường hợp người bệnh đang dùng ống thông tiểu
-
Hệ tiêu hóa
Một số tình trạng nhiễm trùng ở đường tiêu hóa cũng có thể gây nhiễm trùng đường huyết, nhất là tình trạng viêm ruột thừa, viêm ruột, nhiễm trùng trong khoang bụng, nhiễm trùng túi mật hoặc gan,...
-
Hệ thần kinh trung ương
Viêm màng não hoặc tủy sống nặng, không được cấp cứu và điều trị kịp thời có thể diễn tiến thành nhiễm trùng huyết, nguy cơ cao đe dọa đến tính mạng
-
Da
Vi khuẩn có thể xâm nhập vào da thông qua vết thương, vị trí viêm hoặc các lỗ hở do ống thông cà ống truyền tĩnh mạch tạo ra, gây nhiễm trùng huyết.

3. Triệu chứng nhận biết nhiễm trùng huyết
Triệu chứng nhiễm trùng huyết khá đa dạng, trong đó phổ biến nhất là:
Triệu chứng thông thường
• Các vấn đề về tiết niệu như đi tiểu ít
• Mệt mỏi, mất năng lượng
• Nhịp tim nhanh
• Huyết áp thấp
• Sốt nhiễm trùng huyết hoặc hạ thân nhiệt
• Run rẩy, ớn lạnh
• Da đổ mồ hôi
• Thở nhanh hoặc khó thở
• Lừ đừ, bứt rứt, khó chịu
Triệu chứng sốc nhiễm trùng huyết
Tình trạng này xảy ra khi tình trạng bệnh không cải thiện, gây tụt huyết áp nghiêm trọng xuống mức nguy hiểm, thường biểu hiện bằng các triệu chứng:
• Thay đổi ý thức, không tỉnh táo
• Da xanh xao
• Môi khô, lưỡi dơ
• Mạch nhanh
• Huyết áp tụt
• Thở nhanh, thở co kéo, thở mệt bất thường

4. Các biến chứng nhiễm trùng huyết
Nếu không được can thiệp và điều trị kịp thời thì nhiễm trùng huyết có thể gây ra những biến chứng nguy hiểm như:
• Rối loạn tri giác
• Viêm đau khớp và cơ
• Giảm chức năng nhận thức
• Suy nội tạng
• Nhiễm trùng tái phát
• Tử vong
5. Cách chẩn đoán nhiễm trùng huyết
Bệnh nhiễm trùng huyết được chẩn đoán dựa trên các tiêu chuẩn, cụ thể như:
• Nhiệt độ cơ thể
• Nhịp tim
• Nhịp thở
• Huyết áp
• Tinh thần
Có thể chẩn đoán nhiễm trùng huyết bằng các phương pháp dưới đây:
• Xét nghiệm máu: Giúp phát hiện dấu hiệu nhiễm trùng, các chức năng cơ chế đông máu, chức năng gan, thận, nồng độ oxy trong máu thấp
• Xét nghiệm chẩn đoán hình ảnh: chụp X- quang, CT, MRI, siêu âm
• Xét nghiệm phân tích nước tiểu
• Xét nghiệm nước bọt
• Xét nghiệm dịch từ vết thương
• Xét nghiệm đàm, dịch từ đường hô hấp
6. Các phương pháp điều trị nhiễm trùng huyết hiệu quả
Người bị nhiễm trùng huyết nặng có thể được điều trị ở phòng chăm sóc đặc biệt của bệnh viện, các phương pháp điều trị có thể:
• Sử dụng thuốc kháng sinh
• Truyền dịch tĩnh mạch (IV)
• Thở oxy
• Sử dụng thuốc vận mạch để co mạch máu và tăng huyết áp
• Sử dụng Insulin để kiểm soát lượng đường trong máu (nếu có rối loạn đường huyết)
• Lọc máu liên tục
• Phẫu thuật để dẫn lưu và làm sạch các ổ nhiễm trùng
Ngoài ra, bản thân mỗi người cũng có thể chủ động bảo vệ sức khỏe của mình trước nguy cơ mắc bệnh nhiễm trùng huyết bằng cách:
• Vệ sinh cá nhân đầy đủ, kỹ lưỡng, rửa tay thường xuyên
• Băng bó các vết thương cho đến khi lành lại
• Tiêm vắc xin đầy đủ theo khuyến nghị
• Theo dõi, khám sức khỏe định kỳ
• Đi khám ngay nếu nghi ngờ bị nhiễm trùng
…………………………………………………………
BỆNH VIỆN ĐA KHOA TTH QUẢNG BÌNH
** Vì sức khỏe và nụ cười của bạn **
• Hotline tư vấn và đăng ký: 0857 867 222
• Hotline tiếp nhận phản ánh: 0967 260 115
• Fanpage: Bệnh viện Đa khoa TTH Quảng Bình
• Địa chỉ: số 99 đường Điện Biên Phủ, phường Phú Hải, TP. Đồng Hới, Quảng Bình
#Benhviendakhoatthquangbinh #TTHQuangBinh




